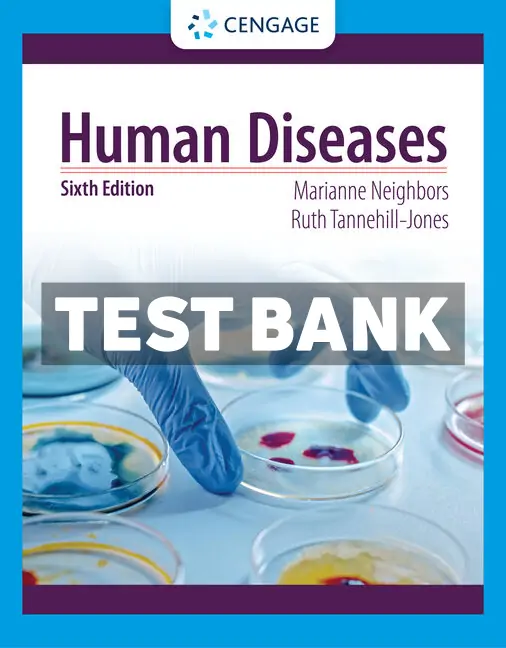

Human Diseases 6th Edition Neighbor Test Bank
$65.00 Original price was: $65.00.$31.00Current price is: $31.00.
Unlock a deeper understanding of human diseases with the “Human Diseases 6th Edition Neighbor Test Bank.” This essential resource is expertly curated to complement your learning, providing comprehensive coverage of critical topics in human diseases. Designed for students and educators alike, it serves as a vital tool for exam preparation and academic success.
Featuring a wide array of meticulously crafted questions and their correct answers, this test bank empowers you to test your knowledge effectively. Each question is aligned with the latest curriculum standards, ensuring that you are not just learning, but mastering the material. Elevate your studies with this organized and efficient study companion.
With instant download available, you have immediate access to all the chapters, all authentically obtained directly from the publishers. This seamless digital access means you can start preparing for your exams without delay, making the “Human Diseases 6th Edition Neighbor Test Bank” a must-have for any serious student or educator in the field.
Maximize Your Learning Potential
Leverage the full benefits of the Human Diseases 6th Edition Neighbor Test Bank to enhance your academic journey. This robust resource is not just a study aid, but a pathway to superior understanding and performance in your human diseases coursework.
- Complete coverage of all the chapters in the “Human Diseases 6th Edition” textbook.
- Instant download access allows you to start studying immediately without any waiting time.
- Authentically sourced from publishers for guaranteed accuracy and completeness.
- Tailored for exam success with questions crafted to reflect real exam scenarios.
- Facilitates deeper learning through well-structured, insightful practice questions and answers.

Reviews
There are no reviews yet.